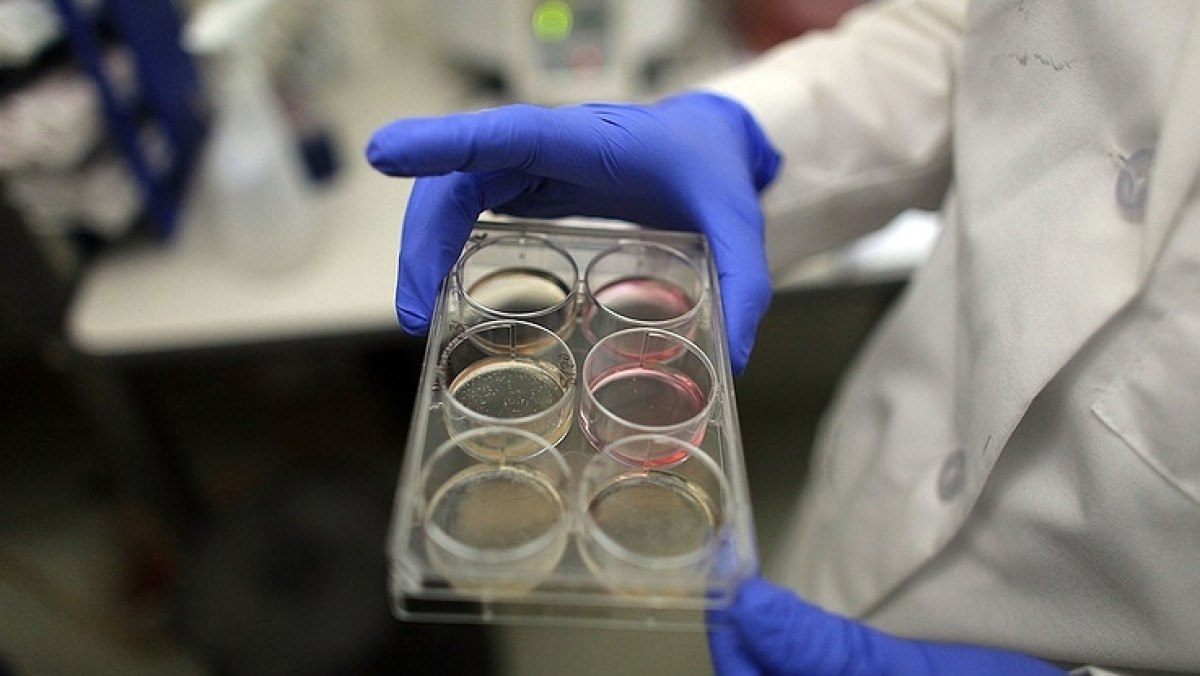
© Spencer Platt/Getty Images, архи

Отмечается, что операция была проведена накануне в медицинском центре города Кобе (префектура Хиого). Донорские iPS-клетки были пересажены пациенту с повреждением части сетчатки глаза. Японские специалисты рассчитывают, что эти специальные стволовые клетки помогут в ее регенерации.
К настоящему моменту клетки не были отторгнуты новым организмом. Сообщается, что в ближайшее время группа исследователей, в которую также вошли специалисты из университетов Киото и Осаки, намереваются провести еще пять аналогичных операций.
После того, как японский ученый Синъя Яманака в 2012 году стал лауреатом Нобелевской премии по медицине и физиологии за исследование в области стволовых клеток, интерес к этой теме как со стороны японского общества, так и со стороны японского правительства многократно возрос. Регенеративная медицина была объявлена одним из приоритетных направлений развития науки.
iPS-клетки при определенном химическом воздействии способны становиться клетками любого типа, что теоретически позволяет выращивать ткани для разных органов. Тем не менее, по мнению ряда специалистов, пересадка выращенных тканей в организм может привести к возникновению злокачественных опухолей.